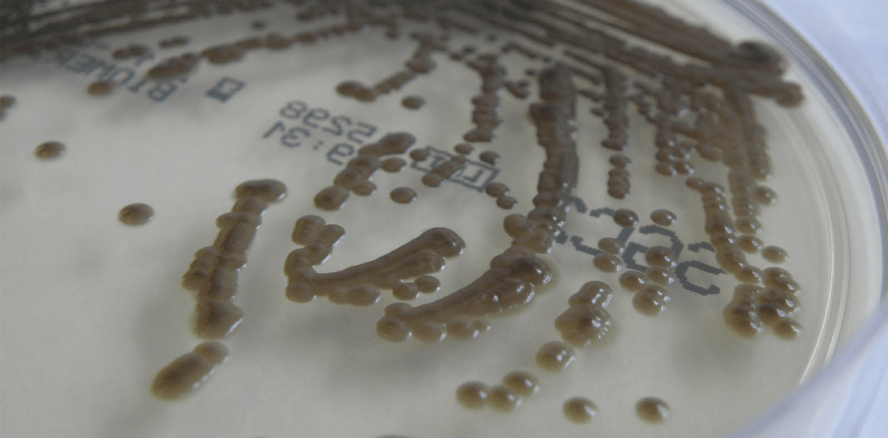
Aquatischer Biofilm, Pilzflora und Reparaturkosten in Dentaleinheiten

Branchenmeldungen 04.04.2016
Aquatischer Biofilm, Pilzflora und Reparaturkosten in Dentaleinheiten
Rechtsnormen einhalten und Kosten sparen durch effizientes Ressourcenmanagement.
Die kostenverursachende Wirkung von aquatischen Biofilmen und Pilzen macht sich besonders in den wasserführenden Kunststoffsystemen dentaler Behandlungseinheiten bemerkbar. Die Materialien werden verstoffwechselt, vergleichbar mit den Kunststofffüllungen in der Zahnmedizin, und dienen so als Nährstoffquelle und damit als Wachstumsfaktor für die im Biofilm siedelnden Mikroorganismen. Biofilme und vor allem Pilze können oftmals zu solch großer Höhe aufwachsen, dass weitere teure Folgeschäden durch Verstopfung von Ventilen und Schläuchen die Folge sind. Dies liegt in der jeweiligen Konstruktion der dentalen Behandlungseinheit, aber auch in der Auswahl ungeeigneter Kunststoffmaterialien begründet (Abb. 1).
Die Betriebsweise der Behandlungseinheit mit naturgemäß hohen Stagnationszeiten und der Herstellervorgabe zur Verwendung biofilmfördernder Wasserentkeimungszusätze, bspw. von Wasserstoffperoxid, welches u. a. gramnegative humanpathogene Biofilmbildner wie Pseudomonas aeruginosa selektiert, verstärken das Problem in Verbindung mit nährstoffreichen Kunststoffen immens (Weihe, S.: Wasserstoffperoxid als Mittel zur kontinuierlichen Dekontamination dentaler Behandlungseinheiten. Diss. Universität Witten/Herdecke, 1995). Die durch Wasserstoffperoxid induzierten chemischen Korrosionsprozesse führen bei Kunststoffen und Metallen zu einem erhöhten Materialverschleiß. Die in Dentaleinheiten siedelnden Mikroorganismen sind dabei häufig widerstandsfähiger gegen die eingesetzten Chemikalien, als das in den Medizinprodukten verbaute Material selbst. Es ist seit Langem bekannt, dass Pseudomonadenbiofilme hohe Wasserstoffperoxidkonzentrationen (H2O2) von drei Prozent ohne Schaden dauerhaft hinnehmen können (Abb. 2), wohingegen Bauteile in dentalen Behandlungseinheiten bereits bei einer Konzentration von 0,05 Prozent H2O2 im Dauerbetrieb Schaden nehmen können. Tropfende, verstopfte Instrumente und hohe Reparaturkosten sind die Folge. Die hiermit einhergehenden mikrobiellen Kontaminationslasten bergen dabei ein erhebliches Rechtsrisiko für die Betreiber von Dentaleinheiten.
Insbesondere finden sich derartige Situationen in den sogenannten freien Ausläufen (Fallstrecken) von dentalen Behandlungseinheiten, die die Becherfüller und Instrumente mit Wasser in Trinkwasserqualität versorgen müssen. Hier kommt es teilweise zu erheblicher Kontamination der Leitungsinnenwandungen mit Mikroorganismen. Diese siedeln sich in Form von Pilzkolonien bevorzugt auf den Kunststoffflächen oberhalb der Wasserlinie an. Der besonders hohe Nährstoffgehalt in der Sicherungseinrichtung führt hier häufig zu einem explosionsartigen Wachstum, sodass die entstandene Biomasse nur noch durch eine manuelle Reinigung oder einen Komplettaustausch des Bauteils beseitigt werden kann. Kommt es dazu, dass über die Trinkwasserinstallation kein Wasser in Trinkwasserqualität gem. TrinkwV an die Behandlungseinheiten gelangt, können diese wiederum gem. MPG nicht betrieben werden. Aufgrund der großen Diversität von Material und Aufbau von Dentaleinheiten ist dies in Problemfällen in der Zahnmedizin ein kaum beherrschbares Problem geworden. Aber auch im Trinkwasserversorgungsbereich sind die Biokorrosion und der Befall mit Exophiala ein signifikanter Kostenfaktor. Es wird also deutlich, wie sehr das Verständnis von aquatischen Biofilmen und Pilzspezies sowohl in der Trinkwasserinstallation als auch in den Dentaleinheiten für Hygienemanagement und Materialschutz eine grundlegende Rolle spielt.
Problemlösungen aus einer Hand
Durch effizientes Management von Ressourcen lassen sich in der zahnmedizinischen Einrichtung, egal welcher Größe – auch bei zunächst bestehenden Defiziten – sowohl die geltenden Rechtsnormen einhalten als auch Kosten sparen. Beispielsweise, wenn es darum geht, alte Behandlungseinheiten konform mit der Trinkwasserverordnung durch den Einsatz eines BLUE SAFETY SAFEBOTTLE Systems zu betreiben. Mit geeigneten technischen Möglichkeiten lässt es sich so vermeiden, Investitionen von gut 35.000 Euro für eine neue Einheit und das Auftreten eines stark kostenverursachenden Exophiala-Befalls zielgerichtet zu vermeiden. In einem anderen Fall können sich durch den Einsatz des SAFEWATER Hygienekonzepts in einer Praxis mit fünf Behandlungseinheiten beispielsweise jährlich bis zu 5.200 Euro einsparen lassen. Über einen Zeitraum von zehn Jahren können sich so über 50.000 Euro an Kostenersparnissen zugunsten der Praxis ergeben.

Wenn es um den abgesicherten (Weiter-)Betrieb von Dentaleinheiten und Kosteneinsparung geht, helfen die Experten von BLUE SAFETY gern weiter.
BLUE SAFETY GmbH
Tel.: 0800 25837233
www.bluesafety.com